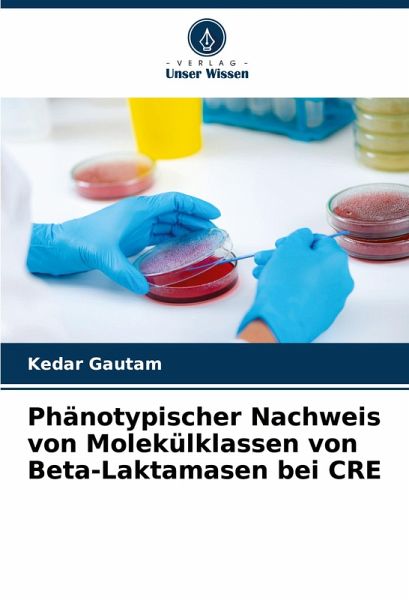

Phänotypischer Nachweis von Molekülklassen von Beta-Laktamasen bei CRE
Versandkostenfrei!
Versandfertig in 6-10 Tagen
61,90 €
inkl. MwSt.
PAYBACK Punkte
0 °P sammeln!
Dieses Buch ist eine Arbeit, die im Kanti Children Hospital, Kathmandu, durchgeführt wurde, um die Belastung durch Carbapenem-resistente Isolate von Enterobacteriaceae, die verschiedene Arten von beta-Lactamasen produzieren, zu bestimmen. Es wurde beobachtet, dass alle Klassen von Carbapenemasen unter den Enterobacteriaceae aufgetaucht sind. Da die beta-Laktamasen von CRE stark variieren, sind wirksame Nachweismethoden in allen klinischen Labors obligatorisch, um das Risiko einer schweren Katastrophe zu verringern.